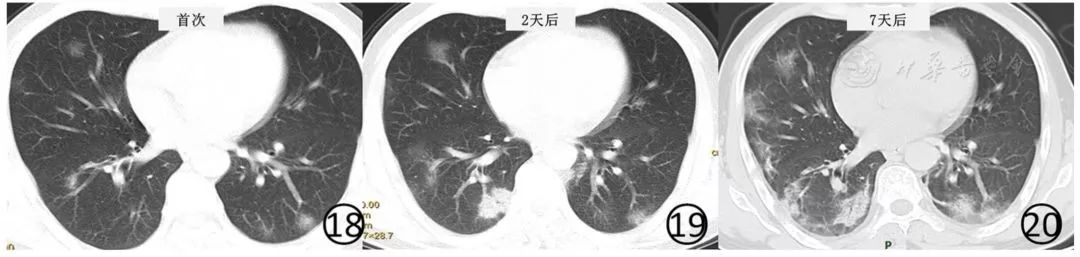
新冠肺炎影像演变过程,新冠肺炎胸部影像学特点有哪些

前言:近期,在新冠肺炎的笼罩下大家都很压抑,昨天,我山接手的武汉“方舱”医院送走了第一批28位“出舱”的病人,而且全国治愈的人数也在不断增加,希望在不久的将来,疫情得到完全控制,所有的患者都能康复出院。
在此,向前线、一线、二线、后备的白衣天使和协调保障的战友们致敬,祝愿战役早日胜利!我们虽不在武汉一线,也希望尽自己的一点力量。

大家都知道,新冠肺炎的诊断中病原学的检测是非常重要的,但实际操作中发现部分患者的核酸检测反复阴性,影像学作为非常重要的检测手段被列为诊断必不可少的诊断依据。上海十院呼吸科的李明教授对此次新冠肺炎的影像学表现做了一个详细的介绍,特别征得同意后转载分享给同道,希望对大家认识本病有所帮助!
闲话少说,直接上图!
放射学表现
PART1
X线表现

图2 男,43岁,新型冠状病毒感染的肺炎。胸部平片显示右中肺野和左肺上、下肺野散在斑片状阴影,边缘不清

图3 男,69岁,新型冠状病毒感染的肺炎。胸部平片显示双肺大片状磨玻璃阴影,右侧为著,其内纹理增粗;右侧水平叶间胸膜部分轻度增厚,右肋膈角变钝,提示少量胸腔积液

图4 男,44岁,新型冠状病毒感染的肺炎。胸部平片显示双肺弥漫性实变,肺门旁空气支气管征,呈"白肺"表现
在新型冠状病毒感染的肺炎,病变早期胸部平片检查多无异常发现。核酸检测阳性的普通型患者多表现为两肺中外带和胸膜下的局限性斑片状或多发节段性片状阴影为主(图2)。
重型患者双肺多发实变影,部分融合成大片状实变,可有少量胸腔积液(图3)。病变进展为危重型,表现为两肺弥漫性实变阴影,呈"白肺"表现(图4),可以伴有少量胸腔积液。
PART2
胸部CT表现
1. 常见 CT 表现
极少数普通型患者起病早期CT无异常发现。随着病变发展肺内可以出现病变。
常见CT表现两肺有多发斑片状磨玻璃阴影 、实变影,多沿支气管血管束和胸膜下分布为主,其间可见增粗的血管影,表现为细网格状影,呈"铺路石征" 。
也可以表现为极为淡薄的磨玻璃阴影,小血管周围有局限性磨玻璃阴影。
病变进展期肺内则表现为磨玻璃阴影、实变、结节等多种性质病变共存,以肺中外带和胸膜下、肺底分布为主,可有纤维化病灶存在。
实变阴影内常见空气支气管征、细支气管管壁有增厚,纤维化病灶则表现为局部肺纹理增粗、扭曲,其内支气管管壁呈柱状,邻近胸膜或叶间胸膜增厚,有少量胸腔积液,无明显淋巴结肿大。
2.CT表现分期
目前尚缺乏系统的放射学表现与病例对照资料研究。基于目前的临床实践,根据病变受累的范围和表现,推荐将新型冠状病毒感染的肺炎CT表现分为3个阶段:早期、进展期和重症期。
(1)早期
表现为单发或多发的局限性磨玻璃阴影、结节(图5,图6),非常淡薄的小斑片磨玻璃阴影(图7,图8)或者大片磨玻璃阴影(图9,图10),多数磨玻璃阴影边缘不清,部分边缘清晰。
病变多分布于中、下叶,多位于胸膜下(图5,图6)或叶间裂下(图7,图8),或者沿支气管血管束分布。
磨玻璃阴影内的细支气管管壁有增厚(图11),可见细支气管的充气支气管征(图11),血管影增粗,边缘欠光整,邻近的叶间胸膜有轻度增厚(图12)。

图5,6 :女,32岁,无发热。CT平扫肺窗显示右肺下叶后段胸膜下(图5)及左肺下叶后段胸膜下(图6)小结节影,周围有晕征

图7,8 :男,38岁。CT平扫横断面(图7)及冠状面(图8)显示右肺下叶内侧段非常淡薄的磨玻璃阴影(红色方框)

图9,10 男,50岁。CT平扫肺窗显示两肺大片磨玻璃阴影和斑片状磨玻璃阴影,多分布于肺的中外带、胸膜下。右侧斜裂有增厚(图9↑),左下后段胸膜下有实变(图10↑)

图11 男,51岁。CT平扫肺窗显示肺内大片和斑片状磨玻璃阴影,其内微血管增多,细支气管有支气管充气征,细支气管壁增厚,左下肺小血管周围有淡薄的磨玻璃阴影(方框)

图12 男,55岁。CT平扫肺窗显示左肺上、下叶见磨玻璃阴影,左侧斜裂胸膜轻度增厚、模糊(红色框内)。右肺下叶背段之亚段性磨玻璃阴影内细支气管柱状增粗(↑),胸膜下局部实变并有小叶间隔增厚、移位。部分病变呈亚段性分布的大片磨玻璃阴影,病变内小血管增多,类似于细网格状阴影或"铺路石征" (图13,图14)。部分磨玻璃阴影有"反晕征" (图15)。

图13,14 男,49岁。CT平扫肺窗显示右上肺(图13)和右下肺(图14)胸膜下有片状磨玻璃阴影,其内可见有增多的细血管阴影表现为网格样,类似于"铺路石征" ,病变内可见细支气管充气支气管征

图15 男,38岁。CT平扫肺窗显示右上肺胸膜下有"反晕征" ,肺内有多发的小斑片状磨玻璃阴影
(2)进展期
病变进展时常见有多发新病灶出现。新病灶CT表现与上述早期病灶相似。
原有病变多数病灶范围扩大,病灶内出现大小、程度不等的实变(图16,图17),有结节和晕征、实变病灶内可见空气支气管征。
原有磨玻璃阴影或实变影也可融合或部分吸收,融合后病变范围和形态常发生变化,不完全沿支气管血管束分布(图18,图19,图20)。

图16,17男,44岁。基线(图16)及4d后(图17)肺CT平扫肺窗显示右肺上叶前段病变范围扩大,局部变密实,并可见空气支气管征,支气管血管束增粗
图18~20 男,46岁。基线(图18)CT平扫显示两肺多发淡薄的磨玻璃阴影,左下肺有结节,周围有晕征,病变位于胸膜下。2d后(图19)及7d后(图20)CT平扫显示病变范围不断扩大,出现新病灶,右下肺实变阴影内有支气管充气征
(3)重症期
病变进一步进展,双肺弥漫性实变,密度不均,其内空气支气管征与支气管扩张,非实变区可呈斑片状磨玻璃阴影表现,双肺大部分受累时呈"白肺"表现(图21),叶间胸膜和双侧胸膜常见增厚,并少量胸腔积液,呈游离积液或局部包裹表现。

图21 男,60岁。CT平扫肺窗显示双肺大部分呈网格状磨玻璃影,背侧明显且部分密实,类"白肺"表现,可见空气支气管征
PART3
放射学表现转归
绝大多数新型冠状病毒感染的肺炎患者经过隔离治疗,病情趋于稳定、好转,表现为病灶范围缩小,密度逐渐减低,病灶数量减少,磨玻璃阴影可完全吸收(图22,图23)。
部分患者病变可以在较短的时间内演变为纤维化的索条影(图24,图25,图26,图27),这种纤维化表现是否为病变逆转的特点,仍有待于资料的进一步积累。
少数具有基础疾病的患者或老年患者,病程中病变进展,肺内病变范围扩大,结构扭曲、变密实,严重时出现"白肺" 。

图22,23 男,48岁。基线(图22)CT平扫肺窗显示多发斑片状磨玻璃阴影和实变,治疗11d后(图23),肺内病变明显吸收、消散,左下肺存留少许纤维化病变

图24~27 男,60岁。首次(图24,25)CT平扫肺窗显示,两肺可见大片状磨玻璃阴影,右肺下叶前段有结节和晕征,新型冠状病毒核酸检测阴性。5 d后(图26,27)CT平扫肺窗显示,大片磨玻璃阴影有吸收,但是出现新发的斑片状磨玻璃阴影,其内有血管增粗,斜裂局限性增厚,两下肺有纤维化形成,其内可见扭曲的细支气管充气征
鉴于目前新型冠状病毒感染的肺炎的转归过程和规律尚不明确。既往一项SARS病例的CT影像纵向研究中,实变影可以转归为磨玻璃阴影或消失,而磨玻璃阴影可持续存在甚至进展为小叶间隔增厚和纤维化、支气管扭曲扩张。
因此,需要大样本、多中心的研究,以便于从放射学的角度探索其演变过程和规律。
放射学在新型冠状病毒感染的肺炎诊断中的作用
放射学检查作为新型冠状病毒感染的肺炎诊断的主要手段之一,放射学诊断的价值在于病变检出、判断病变性质、评估疾病严重程度,以利于临床进行分型。
需要强调的是放射学诊断不是确诊方法。新型冠状病毒核酸检测阳性是诊断新型冠状病毒感染的肺炎的金标准。
据临床实践观察,可以表现为:
①新型冠状病毒核酸检测阳性,但是首次放射学检查阴性,复查时则发现肺内有异常表现(图28,图29);
②无症状,但是有接触史,CT平扫肺内发现病变,后经新型冠状病毒核酸检测阳性证实(图30,图31);
③有流行病学史,肺内有明显的病变,新型冠状病毒核酸检测前几次阴性,最终为新型冠状病毒核酸检测阳性(图32,图33)。

图28,29 男,44岁,有流行病学史,发热1d,体温38.0℃,伴咳嗽、干咳、全身乏力。基线(图28)CT扫描肺内未见异常,新型冠状病毒检测阳性。4d后(图29)复查CT,显示左下肺后段可见磨玻璃阴影

图30,31 男,50岁。患者于2020年1月20日参加有疫源地来源人员聚会,配偶于2020年1月26日确诊为新型冠状病毒感染的肺炎。患者无发热、咳嗽、胸闷、气短等不适,来院要求CT检查。CT平扫肺窗(图30,31)显示两肺多发斑片状磨玻璃阴影和结节。此后新型冠状病毒检测阳性。

图32,33 女,34岁。患者母亲确诊为新型冠状病毒感染的肺炎。本例新型冠状病毒核酸检测前2次阴性,第3次阳性。CT平扫初次检查,肺窗(图32,33)显示左肺大片状磨玻璃阴影,其内伴有细网状影,呈"铺路石征" ,内可见增粗的血管影
目前临床情况比较复杂,在这个特定时间段,放射学检查发现有异常,需要紧密结合其他相关疾病的临床特点,在除外流感、支原体感染后等疾病后,至少需要进行1次,乃至多次新型冠状病毒核酸检测。
对于确诊病例的放射学复查时间窗目前尚无确切的依据,根据对已有病例的观察并结合武汉临床经验,建议:
①临床表现典型、新型冠状病毒核酸检测阳性的初诊患者,初诊胸部CT阴性,推荐3~5d复查胸部CT,观察有无病变出现;
②临床表现不典型,放射学表现具有病毒性肺炎特点的临床诊断病例,除了应该反复查新型冠状病毒核酸检测之外,推荐5~7d复查胸部CT,观察病变的消长;
③确诊病例的非危重症患者,推荐5~7d复查胸部CT,观察病变的消长。检查频次太多,需要注意患者接受辐射剂量问题。对于危重症患者,床旁摄片的检查次数则根据临床需要进行。
出院的放射学依据
新型冠状肺炎经过有效治疗,在符合临床治愈的前提条件下,出院的放射学推荐意见是
①肺内病变范围明显缩小、吸收、完全消散;
②肺内仅存留少许纤维化;
③没有新发病变。
儿童新型冠状病毒感染的肺炎临床特点和放射学表现
(一)家庭聚集性发病为特点
儿童家庭聚集性发病是此次流行病学特点,尤其是儿童患者,系第二代病毒感染,甚至累及新生儿。
(二)新型冠状病毒核酸检测
儿童咽拭新型冠状病毒核酸检测阳性率低于成人。采用肛拭方法、尤其是新生儿是较敏感方法。
( 三)放射学表现
新型冠状病毒感染的肺炎CT表现多样性,以磨玻璃阴影、实变为主,缺乏特异性。一般临床症状轻,肺部病灶较少,常常给诊断带来一定难度。对于疑似病例,CT检查发现肺内异常表现,可以协助早期治疗干预。但是确诊需结合流行病学史、新型冠状病毒检测和放射学表现综合判断。
放射学鉴别诊断
新型冠状病毒感染的肺炎需要与病毒性肺炎(流感病毒肺炎、禽流感肺炎、SARS)、支原体肺炎、细菌性肺炎等鉴别。一般而言按照发病年龄分类:
①儿童社区获得性肺炎前3位的病原菌包括肺炎支原体、细菌、呼吸道合胞病毒;
②成人社区获得性肺炎中病毒感染占15.0%~34.9%,其中流感病毒占首位,其他病毒包括副流感病毒、鼻病毒、腺病毒、人偏肺病毒及呼吸道合胞病毒等。病毒检测阳性患者中5.8%~65.7%可合并细菌或非典型病原体感染;
③其他需要鉴别的疾病有血管炎、急性肺间质性肺炎、结缔组织相关性肺病、隐源性机化性肺炎等。
新型冠状病毒感染的肺炎,在流行病学病史方面与上述疾病有很大不同。目前也是流感的高发季节,在当前的特定时间点,若发现肺内有渗出、实变、结节等影像表现,需要排除普通流感、支原体及细菌后,按照"国家卫健委颁布的新型冠状病毒感染的肺炎诊疗方案(试行第五版)"的标准,结合流行病学病史和临床特点,进行放射学描述性诊断,而最后确诊需要做病原学的核酸检测。
新型冠状病毒感染的肺炎的演变过程和规律还需要有更多的资料积累和进一步的探索和研究。
新型冠状病毒感染的肺炎概述
略过。
放射学检查
(一)放射学检查流程
放射学检查及诊断是新型冠状病毒感染诊疗的重要一环,推荐的放射学检查流程如下(图1)。

图1新型冠状病毒感染的肺炎的影像诊断流程图
(二)DR检查
新型冠状病毒感染的肺炎平片漏诊率高,病变初期多无异常发现,不推荐使用。随病情进展,可表现为局限斑片影或多发实变影。重症者可以表现为"白肺" ,临床上则有严重的低血氧症。
(三)CT检查
新型冠状病毒感染的肺炎放射学检查,首选容积CT扫描,扫描层厚5 mm(16层CT以上均可以达到),重建为1.0~1.5 mm薄层。
基于薄层CT重建,在横断面、矢状面和冠状面观察,有利于病灶早期检出,评估病变性质和范围,发现DR不易观察的细微变化。
致谢:上海市十院呼吸科 李明 教授
疫情期间,不造谣,不信谣,理性认识疾病,客观对待疫情。 祝大家健康、平安、幸福!
1、中国疾控中心提示:病例密切接触者的居家医学观察怎么做?(居家观察篇)
2、中国疾控中心提示:有疾病流行地区居住旅行史人员该怎么做?(旅游预防篇)
3、中国疾控中心提示:在家怎么做?(家庭预防篇)
4、中国疾控中心提示:家庭消毒怎么做?
5、中国疾控中心提示:公共场所怎么做?(公共场所预防篇)
6、中国疾控中心提示:如何处理这些口罩问题?
7、中国疾控中心提示:寒假后返校学生(学生篇)
8、中国疾控中心提示:孕产妇预防(孕产妇篇)
9、中国疾控中心提示:流行期间公众就医(就医篇)
10、中国疾控中心提示:口罩选择和使用(口罩篇)
11、中国疾控中心提示:私家车预防(私家车预防篇)
12、中国疾控中心提示:家庭消毒怎么做?【视频版】
13、WHO推荐流感病毒防护小贴士
14、中国病毒学泰斗闻玉梅院士寄语武汉:科学、参与、信任,疫情两周后定现拐角
15、中国疾控中心提示:慢性病患者预防(慢性病患者预防篇)
16、如何给孩子们做新冠肺炎的科普及防护?
17、人卫出版社 |《新型冠状病毒感染的肺炎公众防护指南》全文
18、中国疾控中心提示:节后返程乘坐火车(乘坐火车篇)
19、中国疾控中心提示:节后返程乘坐地铁公交(地铁公交篇)
20、中国疾控中心提示:疾控中心跟您聊聊居家消毒那些事儿(居家消毒篇)
21、科普:体温高于多少才是发热?怎么测才更准?
22、经典视频集锦来科普新冠肺炎防护,有意思!
23、病毒进入人体内的48小时发生了什么?
24、如何区分感冒流感和新型冠状病毒肺炎?
25、有趣的动画科普:新冠肺炎是怎么传播的?
26、张文宏教授:WHO新型冠状病毒的传言和事实
27、健康最三条:洗手、戴口罩,增强免疫力!